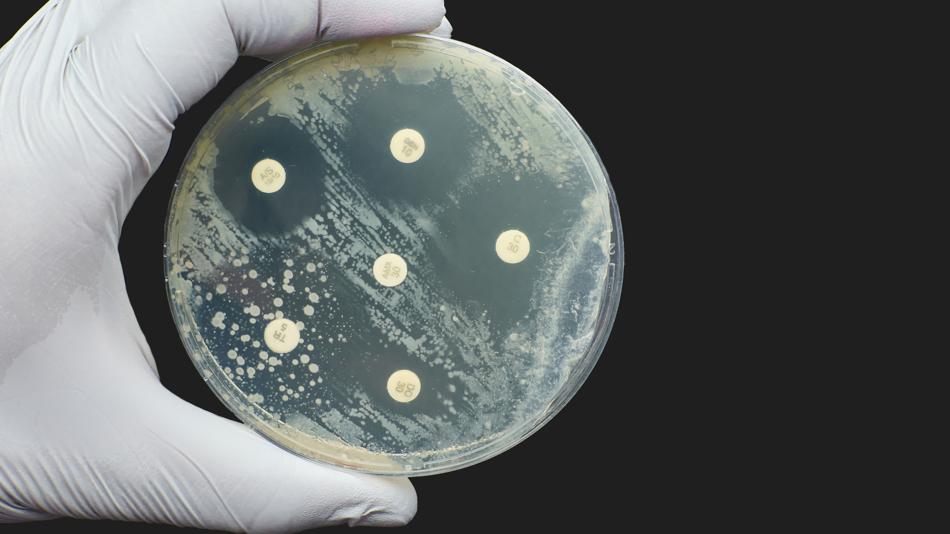
Antibiogramm

Mitmachstation
Wer steckt hinter Infektionen?
Durchschnittliche Verweildauer: 15 Minuten
Maximale Kapazität der Station: 8 Personen
Mikroorganismen sind Teil unseres Lebens und erfüllen wichtige Aufgaben. Bei einem gestörten Gleichgewicht oder einem geschwächten Immunsystem können sie jedoch ernste Infektionen auslösen. Entdecken Sie bei dieser interaktiven Station von Open Science – Lebenswissenschaften im Dialog unterschiedliche Mikroorganismen, erfahren Sie, wo diese vorkommen oder welche Krankheiten sie auslösen können. Die Identifikation von Krankheitserregern ist oft ausschlaggebend, um die richtige Therapie für Patient:innen zu finden. Unter dem Mikroskop können verschiedene Bakterien und Pilze genauer untersucht werden. Weiters lernen Sie Methoden kennen, die bei der Wahl der richtigen Medikamente – insbesondere Antibiotika – helfen.
Besucherinformation
Anfahrtsbeschreibung: Sie erreichen den Vienna BioCenter mit der U3 (Haltestelle Schlachthausgasse), den Straßenbahnlinien 18 und 71 (Haltestelle St. Marx oder Viehmarktgasse) und mit dem Bus 74A (Haltestelle Viehmarktgasse). Da es am Vienna BioCenter keine Parkmöglichkeiten gibt, empfehlen wir dringend die Anreise mit den öffentlichen Verkehrsmitteln. Es gibt vor Ort die Möglichkeit Kinderwägen während des Besuches abzustellen.
Dieser Ausstellungsstandort ist barrierefrei zugänglich und verfügt über barrierefreie Toiletten.
Öffnungszeiten
34 weitere Stationen an diesem Standort
-
 MitmachstationErstaunliche Bärtierchen - winzig und widerstandsfähigThema: Naturwissenschaften UmweltAusgewachsene Bärtierchen sind weniger als 1 mm groß. Man findet sie in lebensfeindlichen Wüsten, giftigen heißen Quellen, auf den höchsten Bergen und in den Tiefen der Ozeane. Sie überleben sogar die Strahlung und das Vakuum des Weltalls, eine Umgebung, die für fast jeden anderen Organismus tödlich wäre. Beobachten Sie, wie diese Survival-Weltmeister zum Leben erwachen!Max Perutz Labs17:00 - 22:30
MitmachstationErstaunliche Bärtierchen - winzig und widerstandsfähigThema: Naturwissenschaften UmweltAusgewachsene Bärtierchen sind weniger als 1 mm groß. Man findet sie in lebensfeindlichen Wüsten, giftigen heißen Quellen, auf den höchsten Bergen und in den Tiefen der Ozeane. Sie überleben sogar die Strahlung und das Vakuum des Weltalls, eine Umgebung, die für fast jeden anderen Organismus tödlich wäre. Beobachten Sie, wie diese Survival-Weltmeister zum Leben erwachen!Max Perutz Labs17:00 - 22:30 -
 MitmachstationDie Organisation unseres GenomsThema: Gesundheit NaturwissenschaftenZellen wissen jeden Tag genau, was sie tun müssen, denn jede einzelne enthält eine Bauanleitung: das Genom. Darin steckt so viel Information, dass man damit 6000 Bücher füllen könnte. Wie ist diese enorme Menge an Information organisiert und was passiert, wenn etwas fehlt? Folgen Sie Ihrem Forschungsdrang indem sie mit Mikroskop und Pipette arbeiten: Können Sie herausfinden, welcher Wurm einen genetischen Defekt hat?Max Perutz Labs17:00 - 22:30
MitmachstationDie Organisation unseres GenomsThema: Gesundheit NaturwissenschaftenZellen wissen jeden Tag genau, was sie tun müssen, denn jede einzelne enthält eine Bauanleitung: das Genom. Darin steckt so viel Information, dass man damit 6000 Bücher füllen könnte. Wie ist diese enorme Menge an Information organisiert und was passiert, wenn etwas fehlt? Folgen Sie Ihrem Forschungsdrang indem sie mit Mikroskop und Pipette arbeiten: Können Sie herausfinden, welcher Wurm einen genetischen Defekt hat?Max Perutz Labs17:00 - 22:30 -
 MitmachstationWozu brauchen wir Enzyme?Thema: Gesundheit NaturwissenschaftenBei dieser Mitmach-Station können die Besucherinnen und Besucher selbst die Pipette in die Hand nehmen und anhand einfacher Experimente die Funktionsweise verschiedener Enzyme erkunden. Sie erfahren dabei u.a. wie laktosefreie Milch hergestellt wird und welche Aufgabe Enzyme in Speichel erfüllen. Wer die wichtigsten Verdauungsenzyme kennenlernen will, kann beim „Dreh dich schlau“-Spiel sein Wissen erweitern.Vienna Open Lab17:00 - 22:30
MitmachstationWozu brauchen wir Enzyme?Thema: Gesundheit NaturwissenschaftenBei dieser Mitmach-Station können die Besucherinnen und Besucher selbst die Pipette in die Hand nehmen und anhand einfacher Experimente die Funktionsweise verschiedener Enzyme erkunden. Sie erfahren dabei u.a. wie laktosefreie Milch hergestellt wird und welche Aufgabe Enzyme in Speichel erfüllen. Wer die wichtigsten Verdauungsenzyme kennenlernen will, kann beim „Dreh dich schlau“-Spiel sein Wissen erweitern.Vienna Open Lab17:00 - 22:30 -
 MitmachstationKönnen Sie uns helfen, die Vergangenheit zu rekonstruieren?Thema: NaturwissenschaftenUm das Puzzle der menschlichen Evolution zu lösen und die Vergangenheit zu rekonstruieren, verbinden Forschende Methoden aus vielen Disziplinen. An dieser Station werden Sie selbst aktiv: Sie ordnen Beweisstücke aus einer archäologischen Ausgrabung, vergleichen Spuren und entwickeln Hypothesen. So lernen Sie Schritt für Schritt, was an diesem Ort geschehen ist und was es über die menschliche Evolution verrät.Universität Wien17:00 - 22:30
MitmachstationKönnen Sie uns helfen, die Vergangenheit zu rekonstruieren?Thema: NaturwissenschaftenUm das Puzzle der menschlichen Evolution zu lösen und die Vergangenheit zu rekonstruieren, verbinden Forschende Methoden aus vielen Disziplinen. An dieser Station werden Sie selbst aktiv: Sie ordnen Beweisstücke aus einer archäologischen Ausgrabung, vergleichen Spuren und entwickeln Hypothesen. So lernen Sie Schritt für Schritt, was an diesem Ort geschehen ist und was es über die menschliche Evolution verrät.Universität Wien17:00 - 22:30 -
 MitmachstationWas verrät uns das Verhalten der Tiere?Thema: Naturwissenschaften UmweltWie arbeiten Verhaltensforscher:innen? Anhand der Modellarten der Konrad Lorenz Forschungsstelle gehen Sie an dieser Station folgenden Fragen nach: Wie kann man Tiere individuell erkennen? Wie kann man ihre Bewegungen verfolgen, ohne sie zu sehen? Was wissen Tiere über ihre Umwelt? Hier erfahren Sie mehr über die Welt der Vögel und lernen die Natur besser kennen!Universität Wien17:00 - 22:30
MitmachstationWas verrät uns das Verhalten der Tiere?Thema: Naturwissenschaften UmweltWie arbeiten Verhaltensforscher:innen? Anhand der Modellarten der Konrad Lorenz Forschungsstelle gehen Sie an dieser Station folgenden Fragen nach: Wie kann man Tiere individuell erkennen? Wie kann man ihre Bewegungen verfolgen, ohne sie zu sehen? Was wissen Tiere über ihre Umwelt? Hier erfahren Sie mehr über die Welt der Vögel und lernen die Natur besser kennen!Universität Wien17:00 - 22:30 -
MitmachstationWie funktioniert eigentlich eine naturwissenschaftliche Fachbibliothek?Thema: Gesellschaft NaturwissenschaftenDie ganze FB Biologie als eine Station! Hier erfahren Sie, was eine naturwissenschaftliche Fachbibliothek ausmacht. Erkunden Sie den Lesesaal und kommen Sie mit den Bibliothekarinnen ins Gespräch. Schmökern Sie durch die Bücher in den Themenräumen oder erkunden Sie die digitalen Bestände an den Recherche-PCs. Für einen Einblick in das Freihandmagazin bieten wir eine Führung um 17:30 und 21:00 Uhr an.Universität Wien17:00 - 22:30
-
 VortragLesung: Wie sprechen eigentlich Elefanten miteinander?Thema: Naturwissenschaften UmweltAngela Stöger liest aus ihrem Buch „Elefanten – Ihre Weisheit, ihre Sprache und ihr soziales Miteinander“ und veranschaulicht das Verhalten der Elefanten mit interessanten Hörbeispielen. Sie erzählt über ihre Forschung zu diesen faszinierenden Tieren und lädt zu Fragen und Diskussionen zum Thema ein. Die Lesung findet im Eingangsbereich der FB Biologie & Botanik statt und startet um 19:30 Uhr.Universität Wien17:00 - 22:30
VortragLesung: Wie sprechen eigentlich Elefanten miteinander?Thema: Naturwissenschaften UmweltAngela Stöger liest aus ihrem Buch „Elefanten – Ihre Weisheit, ihre Sprache und ihr soziales Miteinander“ und veranschaulicht das Verhalten der Elefanten mit interessanten Hörbeispielen. Sie erzählt über ihre Forschung zu diesen faszinierenden Tieren und lädt zu Fragen und Diskussionen zum Thema ein. Die Lesung findet im Eingangsbereich der FB Biologie & Botanik statt und startet um 19:30 Uhr.Universität Wien17:00 - 22:30 -
 MitmachstationWie viel Farbe steckt in unserem Alltag?Thema: NaturwissenschaftenLicht und Farbe beeinflussen unseren Alltag. An dieser Mitmachstation führen Sie einfache Experimente selbst durch, trennen mithilfe von Alltagsgegenständen komplexe Farbmischungen und bestimmen deren Bestandteile. Außerdem erfahren Sie, wie Unsichtbares sichtbar wird, wie Knicklichter funktionieren und wie diese Konzepte in aktueller Forschung angewandt werden.Universität Wien17:00 - 22:30
MitmachstationWie viel Farbe steckt in unserem Alltag?Thema: NaturwissenschaftenLicht und Farbe beeinflussen unseren Alltag. An dieser Mitmachstation führen Sie einfache Experimente selbst durch, trennen mithilfe von Alltagsgegenständen komplexe Farbmischungen und bestimmen deren Bestandteile. Außerdem erfahren Sie, wie Unsichtbares sichtbar wird, wie Knicklichter funktionieren und wie diese Konzepte in aktueller Forschung angewandt werden.Universität Wien17:00 - 22:30 -
 FührungTour: Meeresforschung ohne Meer? Willkommen im Aqualab!Thema: Naturwissenschaften UmweltBesuchen Sie das Aqualab der Universität Wien! Hier schauen Sie selbst durchs Mikroskop, beobachten Meeresorganismen aus nächster Nähe und sprechen mit Forschenden. Erfahren Sie, warum und wie wir Meerestiere ohne Meer erforschen – von Haltung und Fütterung bis zu spannenden Fragen der Biologie.Universität Wien17:00 - 22:30
FührungTour: Meeresforschung ohne Meer? Willkommen im Aqualab!Thema: Naturwissenschaften UmweltBesuchen Sie das Aqualab der Universität Wien! Hier schauen Sie selbst durchs Mikroskop, beobachten Meeresorganismen aus nächster Nähe und sprechen mit Forschenden. Erfahren Sie, warum und wie wir Meerestiere ohne Meer erforschen – von Haltung und Fütterung bis zu spannenden Fragen der Biologie.Universität Wien17:00 - 22:30 -
 MitmachstationTierische Leistung am Limit: von Käferkraft zur menschlichen GeburtThema: Naturwissenschaften UmweltAn dieser Station erleben Sie Leistung am Limit: In einem Wettrennen zeigen Käfer und Schnecken, wie sie ein Vielfaches ihres eigenen Gewichts bewegen können. Eine andere Form von Kraft wird mit 3D-Modellen sichtbar: Wie gut passen Babyköpfe durch die Becken von Menschen und anderen Säugetieren? Und was verrät das über die besonderen Herausforderungen menschlicher Geburten?Universität Wien17:00 - 22:30
MitmachstationTierische Leistung am Limit: von Käferkraft zur menschlichen GeburtThema: Naturwissenschaften UmweltAn dieser Station erleben Sie Leistung am Limit: In einem Wettrennen zeigen Käfer und Schnecken, wie sie ein Vielfaches ihres eigenen Gewichts bewegen können. Eine andere Form von Kraft wird mit 3D-Modellen sichtbar: Wie gut passen Babyköpfe durch die Becken von Menschen und anderen Säugetieren? Und was verrät das über die besonderen Herausforderungen menschlicher Geburten?Universität Wien17:00 - 22:30 -
 MitmachstationVom Bauplan zum Recycling: Das Leben der ProteineThema: Gesundheit NaturwissenschaftenWie wird ein DNA-Code zum funktionalen Protein? Was passiert, wenn in einer Zelle etwas schiefläuft? Und woraus bestehen Zellen überhaupt? Begleiten Sie uns auf einer Entdeckungsreise durch die faszinierende Welt der Zellbiologie! Navigieren Sie durch unser Autophagie-Labyrinth, falten Sie Ihr eigenes Protein und entdecken Sie modernste Protein-Visualisierungssoftware. Werden Sie selbst Forscher oder Forscherin!Max Perutz Labs17:00 - 22:30
MitmachstationVom Bauplan zum Recycling: Das Leben der ProteineThema: Gesundheit NaturwissenschaftenWie wird ein DNA-Code zum funktionalen Protein? Was passiert, wenn in einer Zelle etwas schiefläuft? Und woraus bestehen Zellen überhaupt? Begleiten Sie uns auf einer Entdeckungsreise durch die faszinierende Welt der Zellbiologie! Navigieren Sie durch unser Autophagie-Labyrinth, falten Sie Ihr eigenes Protein und entdecken Sie modernste Protein-Visualisierungssoftware. Werden Sie selbst Forscher oder Forscherin!Max Perutz Labs17:00 - 22:30 -
 MitmachstationWas verraten uns Seeanemonen, Hydren und Quallen über die frühe Evolution der Tiere?Thema: Naturwissenschaften UmweltWerfen Sie mit uns einen Blick durchs Mikroskop und entdecken Sie die Nesseltiere, von winzigen Entwicklungsstadien bis zum ausgewachsenen Tier. Erfahren Sie, wie sie sich fortpflanzen und regenerieren, wie ihre Muskeln arbeiten und ihr Nervensystem funktioniert – und was uns das über die Anfänge des tierischen Lebens verrät. Als Highlight füttern wir die Tiere vor Ihren Augen und zeigen, wie sie jagen und fressen.Universität Wien17:00 - 22:30
MitmachstationWas verraten uns Seeanemonen, Hydren und Quallen über die frühe Evolution der Tiere?Thema: Naturwissenschaften UmweltWerfen Sie mit uns einen Blick durchs Mikroskop und entdecken Sie die Nesseltiere, von winzigen Entwicklungsstadien bis zum ausgewachsenen Tier. Erfahren Sie, wie sie sich fortpflanzen und regenerieren, wie ihre Muskeln arbeiten und ihr Nervensystem funktioniert – und was uns das über die Anfänge des tierischen Lebens verrät. Als Highlight füttern wir die Tiere vor Ihren Augen und zeigen, wie sie jagen und fressen.Universität Wien17:00 - 22:30 -
 MitmachstationWer sind die Superhelden unter unseren Füßen?Thema: Naturwissenschaften UmweltWir laufen jeden Tag darüber – und merken ihn kaum: den Boden unter unseren Füßen. Aber wussten Sie, dass der Boden lebt? Würmer, Pilze und Bakterien arbeiten dort rund um die Uhr im Verborgenen. An unserer Mitmach-Station erkunden Sie diese versteckte Welt spielerisch im Memory und lernen die kleinen Superhelden und ihre Superkräfte kennen. Mit Augen, Händen und Nase erleben Sie die Vielfalt unterschiedlicher Böden.Universität Wien17:00 - 22:30
MitmachstationWer sind die Superhelden unter unseren Füßen?Thema: Naturwissenschaften UmweltWir laufen jeden Tag darüber – und merken ihn kaum: den Boden unter unseren Füßen. Aber wussten Sie, dass der Boden lebt? Würmer, Pilze und Bakterien arbeiten dort rund um die Uhr im Verborgenen. An unserer Mitmach-Station erkunden Sie diese versteckte Welt spielerisch im Memory und lernen die kleinen Superhelden und ihre Superkräfte kennen. Mit Augen, Händen und Nase erleben Sie die Vielfalt unterschiedlicher Böden.Universität Wien17:00 - 22:30 -
 MitmachstationWie bilden Mikroben und Pflanzen eine Partnerschaft unter der Erde?Thema: Naturwissenschaften UmweltEntdecken Sie unter dem Mikroskop, wie Hülsenfrüchte und Bodenbakterien zusammenarbeiten: Rhizobien leben in Wurzelknöllchen, wo sie den Luftstickstoff umwandeln können – ein essenzieller Nährstoff für alle Lebewesen. Sie sehen echte Wurzelsysteme, finden Knöllchen und erfahren, warum diese Symbiose für Landwirtschaft und Nachhaltigkeit so wichtig ist.Universität Wien17:00 - 22:30
MitmachstationWie bilden Mikroben und Pflanzen eine Partnerschaft unter der Erde?Thema: Naturwissenschaften UmweltEntdecken Sie unter dem Mikroskop, wie Hülsenfrüchte und Bodenbakterien zusammenarbeiten: Rhizobien leben in Wurzelknöllchen, wo sie den Luftstickstoff umwandeln können – ein essenzieller Nährstoff für alle Lebewesen. Sie sehen echte Wurzelsysteme, finden Knöllchen und erfahren, warum diese Symbiose für Landwirtschaft und Nachhaltigkeit so wichtig ist.Universität Wien17:00 - 22:30 -
 MitmachstationSchlaue Vögel: Wie knacken Krähen harte Nüsse?Thema: Naturwissenschaften UmweltKrähen sind erstaunlich geschickt, wenn es um Nahrung geht: Sie lassen z.B. Walnüsse fallen, bis sie aufbrechen. An dieser Station finden wir gemeinsam heraus, wie junge Krähen dieses Verhalten erlernen. Sie probieren selbst aus, welche Strategie und welcher Untergrund zum Erfolg führen – und erleben, wie Lernen durch Versuch, Beobachtung oder Vererbung funktioniert.Universität Wien17:00 - 22:30
MitmachstationSchlaue Vögel: Wie knacken Krähen harte Nüsse?Thema: Naturwissenschaften UmweltKrähen sind erstaunlich geschickt, wenn es um Nahrung geht: Sie lassen z.B. Walnüsse fallen, bis sie aufbrechen. An dieser Station finden wir gemeinsam heraus, wie junge Krähen dieses Verhalten erlernen. Sie probieren selbst aus, welche Strategie und welcher Untergrund zum Erfolg führen – und erleben, wie Lernen durch Versuch, Beobachtung oder Vererbung funktioniert.Universität Wien17:00 - 22:30 -
 ShowprogrammPub Quiz: Was wissen Sie über Primatologie und unsere nächsten Verwandten?Thema: Naturwissenschaften UmweltTeamgeist, Wissen und eine Portion Humor sind gefragt: In unserer Primaten-Quizshow treten Sie in Teams gegeneinander an und entdecken spielerisch die faszinierende Welt der Affen – von der Artenvielfalt bis zur Verhaltensbiologie. In 40 Minuten beantworten Sie abwechslungsreiche Fragen, messen Ihr Wissen miteinander, erfahren mehr über das Feld der Primatenforschung und nehmen tolle Preise mit nach Hause!Universität Wien17:00 - 22:30
ShowprogrammPub Quiz: Was wissen Sie über Primatologie und unsere nächsten Verwandten?Thema: Naturwissenschaften UmweltTeamgeist, Wissen und eine Portion Humor sind gefragt: In unserer Primaten-Quizshow treten Sie in Teams gegeneinander an und entdecken spielerisch die faszinierende Welt der Affen – von der Artenvielfalt bis zur Verhaltensbiologie. In 40 Minuten beantworten Sie abwechslungsreiche Fragen, messen Ihr Wissen miteinander, erfahren mehr über das Feld der Primatenforschung und nehmen tolle Preise mit nach Hause!Universität Wien17:00 - 22:30 -
 MitmachstationWo verstecken sich Mikroben und wie sehen sie aus?Thema: Naturwissenschaften UmweltEntdecken Sie die geheime Welt der Mikroben: Sehen Sie Boden-, Wasser- und Darmmikroben im Mikroskop leuchten und lassen Sie sich von ihren interessanten Formen und ihrer Vielfalt überraschen.Universität Wien17:00 - 22:30
MitmachstationWo verstecken sich Mikroben und wie sehen sie aus?Thema: Naturwissenschaften UmweltEntdecken Sie die geheime Welt der Mikroben: Sehen Sie Boden-, Wasser- und Darmmikroben im Mikroskop leuchten und lassen Sie sich von ihren interessanten Formen und ihrer Vielfalt überraschen.Universität Wien17:00 - 22:30 -
 MitmachstationWas wird an der Tropenstation La Gamba geforscht?Thema: Naturwissenschaften UmweltEntdecken Sie die Welt der Tropenstation La Gamba im „Regenwald der Österreicher“ in Costa Rica. Lernen Sie mehr über die Erforschung des tropischen Regenwaldes, seine Artenvielfalt und die Bedeutung des Naturschutzes.Universität Wien17:00 - 22:30
MitmachstationWas wird an der Tropenstation La Gamba geforscht?Thema: Naturwissenschaften UmweltEntdecken Sie die Welt der Tropenstation La Gamba im „Regenwald der Österreicher“ in Costa Rica. Lernen Sie mehr über die Erforschung des tropischen Regenwaldes, seine Artenvielfalt und die Bedeutung des Naturschutzes.Universität Wien17:00 - 22:30 -
 MitmachstationWas hat denn meine Jause mit dem Klima zu tun?Thema: Gesundheit UmweltGemeinsam gehen wir der Frage nach, wie Jause und Klima zusammenhängen: Wie beeinflussen Lebensmittelwahl, Verpackung und Lagerung das Klima? Sie vergleichen Produkte, treffen Alltagsentscheidungen und sammeln Ideen für klimafreundliches Handeln. Nehmen Sie überraschende Aha-Momente für Ihren Jausenalltag mit nach Hause.Universität Wien17:00 - 22:30
MitmachstationWas hat denn meine Jause mit dem Klima zu tun?Thema: Gesundheit UmweltGemeinsam gehen wir der Frage nach, wie Jause und Klima zusammenhängen: Wie beeinflussen Lebensmittelwahl, Verpackung und Lagerung das Klima? Sie vergleichen Produkte, treffen Alltagsentscheidungen und sammeln Ideen für klimafreundliches Handeln. Nehmen Sie überraschende Aha-Momente für Ihren Jausenalltag mit nach Hause.Universität Wien17:00 - 22:30 -
MitmachstationWelche Rolle spielen Samen im Artenschutz?Thema: Naturwissenschaften UmweltWie lassen sich mit kleinsten Samen Arten schützen? An dieser Station entdecken Sie Samen gefährdeter Pflanzenarten und betrachten ihre unterschiedlichen Formen unter dem Mikroskop. Dabei lernen Sie die Arbeitsweisen der Mitarbeiter:innen des Botanischen Gartens kennen. Außerdem erfahren Sie, wie Samenbanken als Reserve für die Zukunft funktionieren und formen eine Samenkugel zum Mitnehmen.Universität Wien17:00 - 22:30
-
 MitmachstationUnsichtbare Allianzen oder mikroskopische Feinde?Thema: Naturwissenschaften UmweltSind Mikroben immer schädlich für Pflanzen? An dieser Station können Sie dieser Fragestellung spielerisch nachgehen. Mit echten Pflanzen, einfachen Spielen, Mikroskop-Demos, Postern und kurzen Erklärungen erleben Sie, wie Mikroben den Pflanzen beim Wachsen und Überleben helfen. Wer tiefer eintauchen möchte, kann an einer Führung durch das Forschungs-Gewächshaus teilnehmen.Universität Wien17:00 - 22:30
MitmachstationUnsichtbare Allianzen oder mikroskopische Feinde?Thema: Naturwissenschaften UmweltSind Mikroben immer schädlich für Pflanzen? An dieser Station können Sie dieser Fragestellung spielerisch nachgehen. Mit echten Pflanzen, einfachen Spielen, Mikroskop-Demos, Postern und kurzen Erklärungen erleben Sie, wie Mikroben den Pflanzen beim Wachsen und Überleben helfen. Wer tiefer eintauchen möchte, kann an einer Führung durch das Forschungs-Gewächshaus teilnehmen.Universität Wien17:00 - 22:30 -
 MitmachstationWie sieht die Welt bei mehr als 1000-facher Vergrößerung aus?Thema: NaturwissenschaftenDie Eigenschaften von Oberflächen spielen in der Forschung eine wichtige Rolle: Ist ein Material glatt oder rau? Hat es Risse oder Furchen? Diese und andere Fragen können mittels Rasterelektronenmikroskopie beantwortet werden. Wollen Sie wissen wie Haare, Pollen, Blätter oder Insekten bei mehr als 1000-facher Vergrößerung aussehen? Bereiten Sie Ihre eigenen Proben vor und lassen Sie sie uns zusammen anschauen!Vienna BioCenter Core Facilities17:00 - 22:30
MitmachstationWie sieht die Welt bei mehr als 1000-facher Vergrößerung aus?Thema: NaturwissenschaftenDie Eigenschaften von Oberflächen spielen in der Forschung eine wichtige Rolle: Ist ein Material glatt oder rau? Hat es Risse oder Furchen? Diese und andere Fragen können mittels Rasterelektronenmikroskopie beantwortet werden. Wollen Sie wissen wie Haare, Pollen, Blätter oder Insekten bei mehr als 1000-facher Vergrößerung aussehen? Bereiten Sie Ihre eigenen Proben vor und lassen Sie sie uns zusammen anschauen!Vienna BioCenter Core Facilities17:00 - 22:30 -
 MitmachstationHOT, COOL und (fast) AUSSERIRDISCH: Wie können Mikroorganismen in extremen Lebensräumen leben?Thema: Naturwissenschaften UmweltGemeinsam entdecken wir die Überlebenskünstler unter den Mikroben: Sie leben in brodelnden Vulkanquellen, in Säurepfützen, Eis und Schnee oder auf dem Boden des Ozeans. Ja manche trotzen sogar Weltraum-Strahlung! An dieser Station können Sie selbst einen Mini-Vulkan bauen, Extrem-Lebensräume und deren Mikroben erforschen und lernen, welche Tricks diese „Extremophilen“ nutzen, um zu überleben.Universität Wien17:00 - 22:30
MitmachstationHOT, COOL und (fast) AUSSERIRDISCH: Wie können Mikroorganismen in extremen Lebensräumen leben?Thema: Naturwissenschaften UmweltGemeinsam entdecken wir die Überlebenskünstler unter den Mikroben: Sie leben in brodelnden Vulkanquellen, in Säurepfützen, Eis und Schnee oder auf dem Boden des Ozeans. Ja manche trotzen sogar Weltraum-Strahlung! An dieser Station können Sie selbst einen Mini-Vulkan bauen, Extrem-Lebensräume und deren Mikroben erforschen und lernen, welche Tricks diese „Extremophilen“ nutzen, um zu überleben.Universität Wien17:00 - 22:30 -
 MitmachstationWie funktioniert Evolution wirklich?Thema: Naturwissenschaften UmweltEvolution zum Anfassen: Entlang einer Zeitlinie entdecken Sie, wie sich unser Wissen seit Darwin entwickelt hat und wie die Natur über Generationen hinweg nützliche Eigenschaften „auswählt“. Warum haben Giraffen lange Hälse? Warum haben Eisbären dickes Fell? Kinder ab 10 Jahren spielen ein Brettspiel und begleiten ein Wesen durch die natürliche Auslese. So wird klar, wie Zufall und Auswahl zusammenwirken.Universität Wien17:00 - 22:30
MitmachstationWie funktioniert Evolution wirklich?Thema: Naturwissenschaften UmweltEvolution zum Anfassen: Entlang einer Zeitlinie entdecken Sie, wie sich unser Wissen seit Darwin entwickelt hat und wie die Natur über Generationen hinweg nützliche Eigenschaften „auswählt“. Warum haben Giraffen lange Hälse? Warum haben Eisbären dickes Fell? Kinder ab 10 Jahren spielen ein Brettspiel und begleiten ein Wesen durch die natürliche Auslese. So wird klar, wie Zufall und Auswahl zusammenwirken.Universität Wien17:00 - 22:30 -
MitmachstationWelchen Einfluss können Menschen auf wilde Tiere haben?Thema: Naturwissenschaften UmweltWerden Sie zu Forschenden und entdecken Sie wie Umweltveränderungen Wildtiere beeinflussen. Üben Sie die Probenentnahme am Krokodil-Modell und zählen sie Atemzüge von Vögeln, um Stress bei Wildtieren zu messen. Lernen Sie Vögel zu beringen, um ihre Zugrouten verfolgen zu können. So erfahren Sie, warum diese Daten wichtig für den Schutz wilder Tiere und ihre Anpassung an den Klimawandel sind.Universität Wien17:00 - 22:30
-
 MitmachstationWie natürlich sind eigentlich Medikamente?Thema: Gesundheit NaturwissenschaftenBei dieser Station können Sie aus Rotkohl Schritt für Schritt farbige Naturstoffe mit Haushaltsmaterialien extrahieren und erzeugen damit spektakuläre Farbumschläge. Auf Filterpapier testen Sie die antioxidative Wirkung und kommen mit Forschenden ins Gespräch: Wie wird aus einem Naturprodukt ein wirksames Medikament – von Weidenrinde zu Acetylsalicylsäure?Universität Wien17:00 - 22:30
MitmachstationWie natürlich sind eigentlich Medikamente?Thema: Gesundheit NaturwissenschaftenBei dieser Station können Sie aus Rotkohl Schritt für Schritt farbige Naturstoffe mit Haushaltsmaterialien extrahieren und erzeugen damit spektakuläre Farbumschläge. Auf Filterpapier testen Sie die antioxidative Wirkung und kommen mit Forschenden ins Gespräch: Wie wird aus einem Naturprodukt ein wirksames Medikament – von Weidenrinde zu Acetylsalicylsäure?Universität Wien17:00 - 22:30 -
 MitmachstationWelche Wege geht der Dünger?Thema: Naturwissenschaften UmweltSpielen Sie unser Spiel und finden Sie heraus, welche Wege Sie als Dünger gehen können! Werden Sie uns helfen die Menschheit zu ernähren oder werden Sie Klimaerwärmung, Luft- oder Wasserverschmutzung verursachen?Universität Wien17:00 - 22:30
MitmachstationWelche Wege geht der Dünger?Thema: Naturwissenschaften UmweltSpielen Sie unser Spiel und finden Sie heraus, welche Wege Sie als Dünger gehen können! Werden Sie uns helfen die Menschheit zu ernähren oder werden Sie Klimaerwärmung, Luft- oder Wasserverschmutzung verursachen?Universität Wien17:00 - 22:30 -
 MitmachstationWie wählen Tiere ihre Partner?Thema: Naturwissenschaften UmweltWie entsteht Attraktivität im Tierreich? Hier sehen Sie kurze Animationen von Balzplätzen der Laubenvögel, von visuellen Täuschungen bei Fischen sowie den Tänzen der Paradiesvögel. Sie erleben selbst, was Farben, Formen und Rhythmus bewirken und lernen, wie die Evolution diese Faktoren gezielt nutzt, um Attraktivität zu erzeugen und was das über den Schönheitssinn von Tieren verrät.Universität Wien17:00 - 22:30
MitmachstationWie wählen Tiere ihre Partner?Thema: Naturwissenschaften UmweltWie entsteht Attraktivität im Tierreich? Hier sehen Sie kurze Animationen von Balzplätzen der Laubenvögel, von visuellen Täuschungen bei Fischen sowie den Tänzen der Paradiesvögel. Sie erleben selbst, was Farben, Formen und Rhythmus bewirken und lernen, wie die Evolution diese Faktoren gezielt nutzt, um Attraktivität zu erzeugen und was das über den Schönheitssinn von Tieren verrät.Universität Wien17:00 - 22:30 -
 MitmachstationWie funktioniert ein Antikörper-Titer-Test?Thema: GesundheitWie ist mein Immunstatus? Habe ich schützende Antikörper gegen Infektionskrankheiten? Hat mein Immunsystem erfolgreich auf eine Impfung reagiert? Bei dieser Mitmach-Station erfahren unsere jungen Besucher:innen in spielerischer Art und Weise, anhand überdimensionaler Modelle, wie moderne immunologische Nachweissysteme funktionieren und wie sie helfen, diese und andere komplexe Fragen zu beantworten.Thermo Fisher Scientific17:00 - 22:30
MitmachstationWie funktioniert ein Antikörper-Titer-Test?Thema: GesundheitWie ist mein Immunstatus? Habe ich schützende Antikörper gegen Infektionskrankheiten? Hat mein Immunsystem erfolgreich auf eine Impfung reagiert? Bei dieser Mitmach-Station erfahren unsere jungen Besucher:innen in spielerischer Art und Weise, anhand überdimensionaler Modelle, wie moderne immunologische Nachweissysteme funktionieren und wie sie helfen, diese und andere komplexe Fragen zu beantworten.Thermo Fisher Scientific17:00 - 22:30 -
 MitmachstationBauen Sie Ihre eigene molekulare MaschineThema: Gesundheit NaturwissenschaftenHaben Sie sich schon einmal gefragt, was im Inneren unserer Zellen passiert? An diesem Ort befinden sich unzählige Proteine – Moleküle, die komplexe Maschinen bilden und lebenswichtige Aufgaben erfüllen. An unserer Station lernen Sie, wie Forschende einzelne Proteine aus dem Zellchaos isolieren, um ihre Eigenschaften zu verstehen. Meistern Sie verschiedene Aktivitäten und nehmen Sie ihr isoliertes "Protein" mit!Max Perutz Labs17:00 - 22:30
MitmachstationBauen Sie Ihre eigene molekulare MaschineThema: Gesundheit NaturwissenschaftenHaben Sie sich schon einmal gefragt, was im Inneren unserer Zellen passiert? An diesem Ort befinden sich unzählige Proteine – Moleküle, die komplexe Maschinen bilden und lebenswichtige Aufgaben erfüllen. An unserer Station lernen Sie, wie Forschende einzelne Proteine aus dem Zellchaos isolieren, um ihre Eigenschaften zu verstehen. Meistern Sie verschiedene Aktivitäten und nehmen Sie ihr isoliertes "Protein" mit!Max Perutz Labs17:00 - 22:30 -
 MitmachstationSchauen Sie! …all die Dinge an, die wir nicht sehen könnenThema: Gesundheit NaturwissenschaftenWas ist das kleinste Ding, das Sie jemals gesehen haben? Die Welt um uns herum besteht aus unzähligen winzigen Teilchen. Unsere Augen können jedoch nichts erkennen, das kleiner als ein menschliches Haar ist – zumindest nicht ohne Mikroskop! Entdecken Sie, was wir mit einem Mikroskop sehen können, wie diese Dinge funktionieren und wie beeindruckend manche im Dunkeln leuchten!Max Perutz Labs17:00 - 22:30
MitmachstationSchauen Sie! …all die Dinge an, die wir nicht sehen könnenThema: Gesundheit NaturwissenschaftenWas ist das kleinste Ding, das Sie jemals gesehen haben? Die Welt um uns herum besteht aus unzähligen winzigen Teilchen. Unsere Augen können jedoch nichts erkennen, das kleiner als ein menschliches Haar ist – zumindest nicht ohne Mikroskop! Entdecken Sie, was wir mit einem Mikroskop sehen können, wie diese Dinge funktionieren und wie beeindruckend manche im Dunkeln leuchten!Max Perutz Labs17:00 - 22:30 -
 MitmachstationWie entwickelt sich ein Fisch?Thema: NaturwissenschaftenWie schafft es der Zebrafisch sich binnen eines Tages aus einem Zellhaufen zu einem schwimmenden Fisch zu entwickeln? Beobachten Sie mit Hilfe eines Mikroskops, wie Zebrafische wachsen und finden Sie heraus, ab welchem Stadium der Herzschlag sichtbar ist oder wann sie ihre Pigmentzellen entstehen. Außerdem können Sie die lustigen Tierchen sehen, mit denen kleine und größere Zebrafische gefüttert werden.Forschungsinstitut für Molekulare Pathologie (IMP)17:00 - 22:30
MitmachstationWie entwickelt sich ein Fisch?Thema: NaturwissenschaftenWie schafft es der Zebrafisch sich binnen eines Tages aus einem Zellhaufen zu einem schwimmenden Fisch zu entwickeln? Beobachten Sie mit Hilfe eines Mikroskops, wie Zebrafische wachsen und finden Sie heraus, ab welchem Stadium der Herzschlag sichtbar ist oder wann sie ihre Pigmentzellen entstehen. Außerdem können Sie die lustigen Tierchen sehen, mit denen kleine und größere Zebrafische gefüttert werden.Forschungsinstitut für Molekulare Pathologie (IMP)17:00 - 22:30 -
 MitmachstationKrebs verstehen – von der Entstehung zur TherapieThema: NaturwissenschaftenWie entsteht Krebs und worin unterscheiden sich Krebszellen von gesunden Zellen? An unserer Station erfahren Sie, wie die moderne Forschung neue Therapien entwickelt. Untersuchen Sie unter dem Mikroskop leuchtende Krebszellen, lernen Sie gesundes Gewebe von Tumorzellen zu unterscheiden und sehen Sie in einem Video Immunzellen in Aktion.Forschungsinstitut für Molekulare Pathologie (IMP)17:00 - 22:30
MitmachstationKrebs verstehen – von der Entstehung zur TherapieThema: NaturwissenschaftenWie entsteht Krebs und worin unterscheiden sich Krebszellen von gesunden Zellen? An unserer Station erfahren Sie, wie die moderne Forschung neue Therapien entwickelt. Untersuchen Sie unter dem Mikroskop leuchtende Krebszellen, lernen Sie gesundes Gewebe von Tumorzellen zu unterscheiden und sehen Sie in einem Video Immunzellen in Aktion.Forschungsinstitut für Molekulare Pathologie (IMP)17:00 - 22:30 -
 MitmachstationVom Virus zur Impfung - Was braucht es zur Entwicklung von Impfstoffen?Thema: Gesundheit NaturwissenschaftenTauchen Sie ein in die faszinierende Welt der Wissenschaft und arbeiten Sie Seite an Seite mit Forschern an der Entwicklung von Impfstoffen gegen Viren, für die es bislang noch keine wirksamen Mittel gibt. Diese Station entführt Sie auf eine Entdeckungsreise, die zeigt, wie ein Virus/Erreger zum Ausgangspunkt für lebensrettende Impfstoffe wird.Valneva Austria GmbH17:00 - 22:30
MitmachstationVom Virus zur Impfung - Was braucht es zur Entwicklung von Impfstoffen?Thema: Gesundheit NaturwissenschaftenTauchen Sie ein in die faszinierende Welt der Wissenschaft und arbeiten Sie Seite an Seite mit Forschern an der Entwicklung von Impfstoffen gegen Viren, für die es bislang noch keine wirksamen Mittel gibt. Diese Station entführt Sie auf eine Entdeckungsreise, die zeigt, wie ein Virus/Erreger zum Ausgangspunkt für lebensrettende Impfstoffe wird.Valneva Austria GmbH17:00 - 22:30









